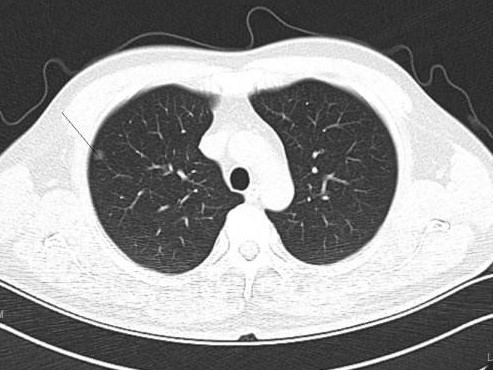
肺部结节

肺部结节如果属于肺癌,有以下几种特征:
1. 毛刺:肺部结节周围呈现短毛刺状,类似于太阳周围的毫光,密集且较为均匀,需警惕肺癌的可能性。
2. 密度:一般来说,纯磨玻璃结节相对于实性结节恶性的概率较大;混合型磨玻璃结节密度相对于磨玻璃结节高一些,其中纯磨玻璃结节密度最低。
3. 分叶:若结节呈现非常均匀的圆形团块状,大部分为良性结节;若结节表面凸凹不平,类似不规则的土豆,恶性的概率较高。
4. 分界:结节与周围正常肺组织分界不清,恶性的概率较大。
5. 空泡:结节中央有空泡,相对于没有空泡的结节,恶性的概率较高。
6. 胸膜牵拉或胸膜凹陷征:这是恶性表现之一。
值得注意的是,对于非专业人士,可以记住以下一点:若结节在随访过程中增大,恶性的概率会较高;若结节缩小,基本上可以排除肺癌的可能性。
当发现肺部结节有上述特征时,建议及时就医,专业医生会根据具体情况判断是否需要进行手术切除。手术切除后,部分患者可能需要进行化疗,以降低复发和转移的风险。老中医在线预约咨询 电话:010-87876186